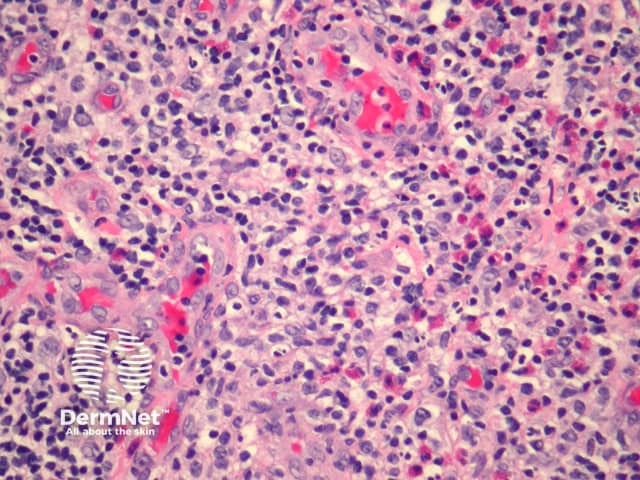
Figure 3

Main menu
Common skin conditions
NEWS
Join DermNet PRO
Read more
Quick links
Lesions (benign) Diagnosis and testing
Author: A/Prof Patrick Emanuel, Dermatopathologist, Auckland, New Zealand, 2013.
Introduction Histology Special studies Differential diagnoses
Angiolymphoid hyperplasia with eosinophilia (or eosinophils) is also known as epithelioid or histiocytoid haemangioma (See also Epithelioid haemangioma pathology). It usually effects young adults and presents as clustered small, translucent nodules on the head and neck.
Sections show an inflamed dermis which shows increased vascularity (figure 1). Higher power examination reveals the endothelial cells lining the vessels are enlarged and epithelioid (figure 2, 3). The infiltrate is composed of lymphocytes which form follicles and numerous eosinophils (figures 2, 3).

Figure 1

Figure 2
Figure 3
None are generally needed.
Kimura disease – Can closely resemble angiolymphoid hyperplasia with eosinophilia. Eosinophilic abscess, eosinophils infiltrating germinal centers and dermal sclerosis are more common in Kimura disease. The vessels of Kimura disease generally lack an epithelioid endothelial lining.